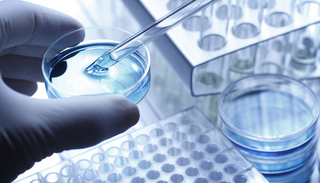

界面新闻记者 |
界面新闻编辑 | 刘海川
2023年3月7日,据新华社消息,根据国务院关于提请审议国务院机构改革方案的议案(简称“改革方案”),重新组建科学技术部。
“从本轮国务院机构改革方案可以看出,科技工作得到高度重视。通过机构改革,理顺科技创新体系,明晰职责,各部门的运作就更加高效,对于科技创新的促进作用也会进一步凸显。” 中国人民大学公共管理学院教授马亮向界面新闻介绍。
改革方案指出,加强科学技术部推动健全新型举国体制、优化科技创新全链条管理、促进科技成果转化、促进科技和经济社会发展相结合等职能,强化战略规划、体制改革、资源统筹、综合协调、政策法规、督促检查等宏观管理职责,保留国家基础研究和应用基础研究、国家实验室建设、国家科技重大专项、国家技术转移体系建设、科技成果转移转化和产学研结合、区域科技创新体系建设、科技监督评价体系建设、科研诚信建设、国际科技合作、科技人才队伍建设、国家科技评奖等相关职责,仍作为国务院组成部门。
改革方案介绍,将科学技术部的组织拟订科技促进农业农村发展规划和政策、指导农村科技进步职责划入农业农村部。将科学技术部的组织拟订科技促进社会发展规划和政策职责分别划入国家发展和改革委员会、生态环境部、国家卫生健康委员会等部门。将科学技术部的组织拟订高新技术发展及产业化规划和政策,指导国家自主创新示范区、国家高新技术产业开发区等科技园区建设,指导科技服务业、技术市场、科技中介组织发展等职责划入工业和信息化部。将科学技术部的负责引进国外智力工作职责划入人力资源和社会保障部,在人力资源和社会保障部加挂国家外国专家局牌子。
此外,深化财政科技经费分配使用机制改革,完善中央财政科技计划执行和专业机构管理体制,调整科学技术部的中央财政科技计划(专项、基金等)协调管理、科研项目资金协调评估等职责,将科学技术部所属中国农村技术开发中心划入农业农村部,中国生物技术发展中心划入国家卫生健康委员会,中国21世纪议程管理中心、科学技术部高技术研究发展中心划入国家自然科学基金委员会。
国家自然科学基金委员会仍由科学技术部管理。科学技术部不再保留国家外国专家局牌子。
马亮介绍,以前科学技术部科研经费分配这部分的职责比较强,基本上是围绕这个方面来去开展工作,这就可能会出现过多精力投入于科研经费相关的事务性工作,而对科研整体的统筹协调作用偏弱的情况。这次机构改革剥离出科技部的一些科研项目、科研经费的具体管理的职责,划归到相关专业的部委,更多凸显出科技部对整个国家科技体制机制的统筹作用。
“本轮机构改革后,可以看出,科技部的超然性,或者说顶层设计的职责会更增强一些。重组科技部后,科技创新的新型举国体制能够进一步健全,同时也能让我们国家在一些卡脖子的关键科研科技领域,具有前瞻性和引领性,避免陷入被动的局面。” 马亮说。
马亮介绍,科研经费的管理等工作划归到相关的部委以后,科技部其实就负责科研工作的“两头”,一头是科研项目前期的规划和统筹,另一头是科研项目的验收和评审,相当于科技部扮演着“裁判员”的角色,这也是在贯彻决策、执行、监督环节相对独立的原则。明显可以看出,机构改革是希望科技部在更高层面对全国的科技创新体系进行规划,对全国的科技创新活动进行评审。这样就能把全国的科技创新工作统领起来,真正形成全国科技创新的一盘棋。
此外,各个专业部委对于专家资源的掌握、对专业方向的把握、对专业领域的管理,会更具优势。“但国务院机构改革只是机构改革中的一半,党中央的机构改革方案尚未公布,后续很有可能会谈到新型举国体制怎么建构的问题。” 马亮表示,届时可能会有类似科技领导小组的机构,对所有相关部委涉及到科技创新的工作进行组织,进行评审,起到统领和整合的作用。
